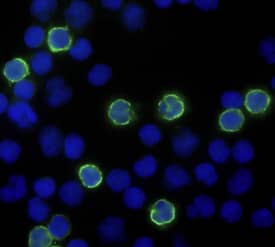
CD8a antibody in Human PBMCs by Immunocytochemistry (ICC).

Human CD8 alpha Alexa Fluor® 488-conjugated Antibody
R&D Systems, part of Bio-Techne | Catalog # FAB1509G


Key Product Details
Species Reactivity
Applications
Label
Antibody Source
Product Specifications
Immunogen
Ser22-Val198
Accession # NP_741969
Specificity
Clonality
Host
Isotype
Scientific Data Images for Human CD8 alpha Alexa Fluor® 488-conjugated Antibody
Detection of CD8 alpha in Human Blood Lymphocytes by Flow Cytometry.
Human peripheral blood lymphocytes were stained with (A) Mouse Anti-Human CD8a Alexa Fluor® 488-conjugated Monoclonal Antibody (Catalog # FAB1509G) or (B) Mouse IgG2B isotype control antibody (Catalog # IC003G) and Mouse Anti-Human CD3e APC-conjugated Monoclonal Antibody (Catalog # FAB100A). View our protocol for Staining Membrane-associated Proteins.CD8 alpha in Human PBMCs.
CD8 alpha was detected in immersion fixed human peripheral blood mononuclear cells (PBMCs) using Mouse Anti-Human CD8 alpha Alexa Fluor® 488‑conjugated Monoclonal Antibody (Catalog # FAB1509G; green) at 10 µg/mL for 3 hours at room temperature. Cells were counterstained with DAPI (blue). Specific staining was localized to cell surfaces. View our protocol for Fluorescent ICC Staining of Non-adherent Cells.Applications for Human CD8 alpha Alexa Fluor® 488-conjugated Antibody
Flow Cytometry
Sample: Human peripheral blood lymphocytes
Immunocytochemistry
Sample: Immersion fixed human peripheral blood mononuclear cells (PBMCs)
Reviewed Applications
Read 1 review rated 5 using FAB1509G in the following applications:
Formulation, Preparation, and Storage
Purification
Formulation
Shipping
Stability & Storage
- 12 months from date of receipt, 2 to 8 °C as supplied.
Background: CD8
CD8 is a heterodimeric glycoprotein consisting of an alpha and beta chain. It is expressed on cytolytic T cells and functions in conjunction with the T cell receptor in the recognition of MHC/peptide complexes.
Alternate Names
Entrez Gene IDs
Gene Symbol
UniProt
Additional CD8 Products
Product Specific Notices for Human CD8 alpha Alexa Fluor® 488-conjugated Antibody
This product is provided under an agreement between Life Technologies Corporation and R&D Systems, Inc, and the manufacture, use, sale or import of this product is subject to one or more US patents and corresponding non-US equivalents, owned by Life Technologies Corporation and its affiliates. The purchase of this product conveys to the buyer the non-transferable right to use the purchased amount of the product and components of the product only in research conducted by the buyer (whether the buyer is an academic or for-profit entity). The sale of this product is expressly conditioned on the buyer not using the product or its components (1) in manufacturing; (2) to provide a service, information, or data to an unaffiliated third party for payment; (3) for therapeutic, diagnostic or prophylactic purposes; (4) to resell, sell, or otherwise transfer this product or its components to any third party, or for any other commercial purpose. Life Technologies Corporation will not assert a claim against the buyer of the infringement of the above patents based on the manufacture, use or sale of a commercial product developed in research by the buyer in which this product or its components was employed, provided that neither this product nor any of its components was used in the manufacture of such product. For information on purchasing a license to this product for purposes other than research, contact Life Technologies Corporation, Cell Analysis Business Unit, Business Development, 29851 Willow Creek Road, Eugene, OR 97402, Tel: (541) 465-8300. Fax: (541) 335-0354.
For research use only